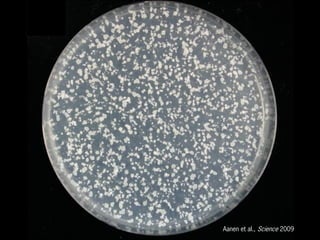
Aanen et al., Science 2009

Recommended
PPT
PDF
Brochure Burgers van der Wal
PDF
PPTX
Lead Pharma, Innovative Medicine door Ad van Gorp
PPTX
Van Buitengewoon Onderwijs naar inclusie, via BNM
PPTX
PDF
Presentatie Zus & Zorg
PPTX
Presentacion 5 actividad 4 la medicion de los cuerpos
PDF
PDF
Special Insight # 38 - Hoe wordt je gelukkig
PDF
PPTX
16 maart 2012 AVS congres Richten van ICT
PPS
PPTX
Adaptieve leersystemen Een Verkenning
PPTX
PPTX
PDF
Grupo Reifs: La pérdida de audición
PPTX
DOC
PDF
PPT
Bessensap2014_Helianthe Kort
PPTX
Bessensap2014_Hans Bennis
PPT
Bessensap2014_Brian Burgoon
PPTX
Bessensap2014_Boris Reuderink
PPTX
Bessensap2014_Annette Janssen
PPTX
Bessensap2014_Judy Shamoun Baranes
PPTX
Bessensap2014_Vanessa Evers
PPT
Bessensap2014_Ruud Peters
PPTX
Bessensap2014_Muriel Hagenaars
PPTX
Bessensap2014_Jeroen van den Bos
More Related Content
PPT
PDF
Brochure Burgers van der Wal
PDF
PPTX
Lead Pharma, Innovative Medicine door Ad van Gorp
PPTX
Van Buitengewoon Onderwijs naar inclusie, via BNM
PPTX
PDF
Presentatie Zus & Zorg
PPTX
Presentacion 5 actividad 4 la medicion de los cuerpos
Viewers also liked
PDF
PDF
Special Insight # 38 - Hoe wordt je gelukkig
PDF
PPTX
16 maart 2012 AVS congres Richten van ICT
PPS
PPTX
Adaptieve leersystemen Een Verkenning
PPTX
PPTX
PDF
Grupo Reifs: La pérdida de audición
PPTX
DOC
PDF
More from NWOBessensap
PPT
Bessensap2014_Helianthe Kort
PPTX
Bessensap2014_Hans Bennis
PPT
Bessensap2014_Brian Burgoon
PPTX
Bessensap2014_Boris Reuderink
PPTX
Bessensap2014_Annette Janssen
PPTX
Bessensap2014_Judy Shamoun Baranes
PPTX
Bessensap2014_Vanessa Evers
PPT
Bessensap2014_Ruud Peters
PPTX
Bessensap2014_Muriel Hagenaars
PPTX
Bessensap2014_Jeroen van den Bos
PPTX
Bessensap2014_Harold Bekkering
PPT
Bessensap2014_Evelien Dekker
PPT
Bessensap2014_Walter van Suijlekom
PPT
PPTX
Bessensap2014_Marleen Kamperman
PPTX
Bessensap2014_Manon van der Heijden
PPTX
Bessensap2014_Hanneke Gelderblom
PDF
Bessensap2014_Francesc Montserrat
PPTX
Bessensap2014_Niels Tuning
Bessensap2014_Duur Aanen 1. 3. 4. 6. 8. Soort Protein (% DW)
Champignon (Agaricus bisporus) 35.7
Oesterzwam (Pleurotus ostreatus) 27.7
Cantharel (Cantharellus cibarius) 22.3
‘Chicken mushroom’ (Termitomyces spp.) 30.1-48.0
Adejumo & Awosanya (2005); Aletor
(1995);Alofe et al. (1996); Parent & Thoen
(1977); Masamba et al. (2010)
9. 10. 12. 15. Competitie is slecht voor de opbrengst
...en daarom onderdrukken boeren competitieve
eigenschappen van hun gewassen en dieren.
20. 21. 22. 23. 24. 25. 27. 28. 29. 30. 31. We kunnen de teeltwijze in het lab nabootsen…
In de kolonie
plant
material
In het lab
32. 33. 34. 35. Opbrengst is positief gecorreleerd met mate van
monocultuur
‘verwantschap’
Gemiddeldeopbrengst(%)
1.000.800.600.400.20
100
75
50
25
0.00
R2=0.864
Aanen et al., Science 2009
36. … maar aantal paddenstoelen negatief.
‘Verwantschap’
Gemiddeldaantalpaddenstoelen(%)
1.000.800.600.400.20
600
500
400
300
200
100
0.00
R2=0.51
Aanen et al., Science 2009
37. 38. 39. Termieten kweken hun schimmel als monocultuur.
Monocultuur
Maximaliseer de opbrengst;
Is stabiel;
En bevordert het mutualisme met termieten.
Maar hoe beïnvloedt langdurige kweek als
monocultuur de schimmel?
40. 41. Leidt langdurige kweek als monocultuur tot een
verlaging van de opbrengst?
16 parallelle lijnen gestart uit een enkele spore
31 keer doorgeënt
42. 43. 44. Na afloop van het experiment is opbrengst
inderdaad verlaagt!
0.00E+00
5.00E+07
1.00E+08
1.50E+08
2.00E+08
2.50E+08
3.00E+08
3.50E+08
4.00E+08
control 9 10 11 12 13 14 15 16Line
Opbrengst
45. Maar hoe houden termieten dan hun opbrengst
stabiel?
Voldoende testen op het niveau van het schimmelindividu
46. 47. Maar hoe houden termieten dan hun opbrengst
stabiel?
Voldoende testen op het niveau van het schimmelindividu
Compartmentalisatie van schimmeltuin, zodat een lokale
daling van productiviteit zich niet door de hele schimmeltuin
verspreidt
48. 49. Maar hoe houden termieten dan hun opbrengst
stabiel?
Voldoende testen op het niveau van het schimmelindividu
Compartmentalisatie van schimmeltuin, zodat een lokale
daling van productiviteit zich niet door de hele schimmeltuin
verspreidt
En misschien: als een kloon minder productief wordt, kan de
schimmel vervangen worden door een nieuwe, productievere
kloon
50.